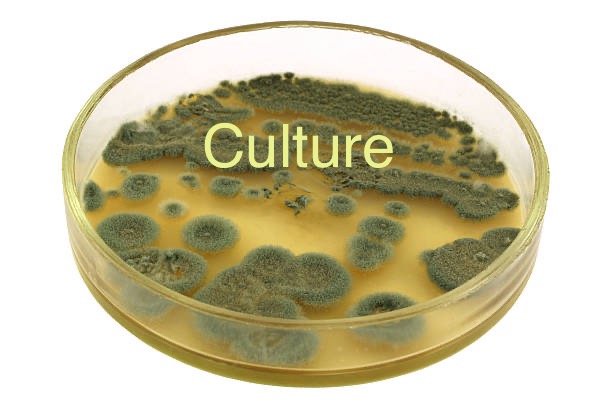

Years ago some neighbors were tasked with naming the neighborhood that would soon be called Wedgewood Houston. James was one of those neighbors and had grown up on these streets. Remembering the dog food plant that was nearby and the countless number of rats that were unleashed when it was demolished he had suggested rat town. Unsurprisingly he didn’t gain much traction. In the end a name was chosen that seemed a lil more appropriate. But our ideas about what makeas a place safe, meaningful, beneficial and interesting are just as much molded by our culture as compiled data.
The purpose of the name “rat town” in Wedgewood Houston, on my truck, and in these pages are meant to probe those cultural norms and characteristics. It is my belief that things aren’t better for humans or the world solely because they are fancier or more expensive. It is also my belief that choosing to value these things while claiming to want equality or a world that is sustainable is grossly incongruous.
What is culture?
Imagine for these pages that it’s a constantly changing democratic “spirit” that exists between/ around us. Because it’s an unwritten agreement between people it would require more than one person. While you could think about it alone, it wouldn’t really be created with a man alone in his basement. That being said it would depend on the needs and desires of the people included. It may very well be different in different neighborhoods and could also change with time.
Art in culture
Those most involved in their culture are normally most involved with the lives of others around them. Conversations that coshape beliefs and values not surprisingly also end up shaping the things that those same people create. From the sharing of lives and needs humans have created tapestries, paintings, literature, clothing, etc. These creations are often used to help explain the values and needs of the individuals in different groups.
Status and being "cultured"
I’ll assume that because of the globalization and spread of Eurocentric culture thru empire, smaller localized cultures lost their felt importance. A need arose to “experience” other cultures. Not necessarily the act of being a part of it or truly experiencing it so much as buying a token or a refrigerator magnet. As European cultures encountered other cultures they would often claim superiority because of the technologies and arts that the European cultures had created. During this era man raced to classify and organize all living things in order of importance with a goal to find new things that could be useful. Unsurprisingly the systems developed to categorize all other living things as lesser would end up being catastrophic to most living things and places.
Community and culture
Those high European arts became more of a statement of status. Often years were required for one to gain the ability to participate. And those observing had to learn the rules of if and when they could react. Meanwhile, I think because of the connection required for the sweeter versions of culture, the humans that had to rely on each other to live instead of competing for a higher place in society, continued to birth meaning from their lives. I’m rarely surprised when the most well off neighborhoods set for themselves the goal of having the “best” in the world. Those places often copy and paste the winners of the awards that they find in a magazine. I’ll also suspect to find the real fun happening in the jazz club in the “shady” part of town. That part of town where you’re less likely to judge others or feel less adequate because of what you don’t have. The part of town where people sometimes need help and know each other well enough to know how to help.

If you’re wanting one come find me, probably late morning on a Sunday. 20 bucks. If any sort of profit is made it’ll be used for some sort of ratification of the neighborhood. Something shared or created with hopes to help people feel more connected to this place.
Why do we move?
Of course people move to new places for many reasons. Conflict and natural disasters force movement, but it’s logically rare for someone to willingly leave a place in which that place gives them everything they need to live a fulfilling life. I’m a bit unsure if a meaningful life or thoughtful mind can exist without place and a context. So, it stands to reason that the person who has moved may need or want something that they’ve felt they weren’t receiving where they were. If a person shows in your community claiming to understand what it needs without having been there long enough to know the place or the people in it, they either presume that every place should be the same or they want to profit from it without being a part of it. Even worse if the owner or ceo lives outside of that neighborhood, or ever worse yet, some undisclosed location out of state, you have enough information to know that any expressed care for the place they own as well as the people that do the actual day to day work required in that place rarely extends further than just words.